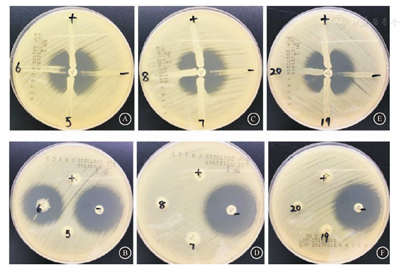

版权归中华医学会所有。
未经授权,不得转载、摘编本刊文章,不得使用本刊的版式设计。
除非特别声明,本刊刊出的所有文章不代表中华医学会和本刊编委会的观点。
碳青霉烯类抗生素广泛应用于治疗多重耐药细菌引起的严重感染,如革兰氏阴性细菌,尤其是产生高水平AmpC酶或ESBLs的菌株。过去的十几年间,耐碳青霉烯的非发酵菌较为普遍,而耐碳青霉烯的肠杆菌科相对少见。但最近几年,耐碳青霉烯的肠杆菌科细菌正在增加[1]。耐碳青霉烯肠杆菌科细菌的耐药机制最常见的是产生能够水解碳青霉烯类抗生素的碳青霉烯酶[2]。本研究通过筛选本院临床分离的耐碳青霉烯肠杆菌科细菌,进行表型检测方法的研究、产酶基因型的分析及产酶菌株的多序列位点分析。通过研究分析掌握本院的碳青霉烯耐药情况并比较临床实验室检测碳青霉烯酶的方法。
收集本院2014年1月至2016年6月临床分离耐碳青霉烯类抗生素(美罗培南MIC)肠杆菌科细菌21株,对照菌株包括大肠埃希菌ATCC25922、肺炎克雷伯菌ATCC1705和肺炎克雷伯菌ATCC2146。
仪器:全自动快速生物质谱检测系统(美国Bruker, Microflex LT/SH);全自动微生物分析仪Vitek-2(法国生物梅里埃);PCR扩增仪(杭州Bioter,TC-96/G/H);高速离心机(美国Thermo公司);电泳仪(北京君意,JY300C) ;凝胶成像仪(Alphalmager HP,Protein simple)。试剂:引物(由北京博迈德生物公司合成);2×Taq PCR MasterMix(北京博迈德生物公司);去离子水;MH平板(批号:04982408) ;10 μg美罗培南药敏纸片(Oxoid公司)。
根据美国临床实验室标准化协会(CLSI)判断标准和临床药敏报告,筛选本院2014年1月至2016年6月临床分离的耐碳青霉烯肠杆菌科细菌,共26株。将保存的菌株用血平板传代后置于35℃培养16~20 h,用Bruker MALDI-TOF质谱仪鉴定菌种后再用10 μg美罗培南药敏纸片和MH平板做K-B法药敏复检试验。再次根据CLSI判断标准,筛选耐药菌株21株,剔除5株。
将0.5麦氏单位的大肠埃希菌(ATCC25922)菌液1∶10稀释后,均匀涂布在MH平皿上,中间贴10 μg美罗培南纸片,将试验菌株、肺炎克雷伯菌ATCCBA-1705 (阳性对照)、肺炎克雷伯菌ATCCBA-1706(阴性对照) 以美罗培南药敏纸片为起点,沿离心方向划线,置于35℃培养16~20 h,试验菌株抑菌圈内出现矢状者为阳性。
用10 μL接种环从血平板上挑取一环过夜培养的菌落,溶于分装有400 μL去离子水的Ep管中。漩涡混匀器震荡混匀菌液,用灭菌的镊子夹取10 μg美罗培南药敏纸片放入菌液中并再次震荡混匀,置于35℃培养2 h后取出。将0.5麦氏单位的大肠埃希菌(ATCC25922)菌液密涂MH平板,然后用接种环挑出经过孵育的美罗培南药敏纸片贴于密涂有大肠埃希菌(ATCC25922)MH平板上,再次置于35℃培养6 h后取出观察结果。如果待测菌株产碳青霉烯酶,美罗培南药敏纸片的抑菌圈直径≤6 mm,结果判读为阳性。反之为阴性。以肺炎克雷伯菌ATCCBA-1705作为阳性对照,肺炎克雷伯菌ATCCBA-1706为阴性对照。
对21株菌进行碳青霉烯酶基因筛查。先用煮沸法提取DNA模板:挑取一定量的新鲜菌落(传代24 h内) 悬浊于200 μL去离子水中,沸水浴10 min后,9 600×g离心5 min,吸取上清液于1.5 mL EP管中,于-20℃以下保存备用。引物稀释前先9 600×g离心5 min后,加入对应体积的去离子水,漩涡混匀器混匀,以100 μmol /L为储存液。引物序列见表1[1]。将PCR扩增产物进行1.5%琼脂糖凝胶电泳,电压为80 V,电流为100 mA。电泳完毕后琼脂糖凝胶置于凝胶成像仪成像,检测是否有目的条带。基因测序PCR阳性扩增产物送北京博迈德生物公司纯化后双向测序,序列经BLAST比对分析,以明确耐药基因型。

碳青霉烯酶基因引物序列
碳青霉烯酶基因引物序列
| 碳青霉烯酶基因 | 引物序列(5′-3′) | 产物大小(bp) | |
|---|---|---|---|
| ClassA | |||
| KPC | F: CTTGTCTCTCATGGCCGCTGG | ||
| R: ACGGAACGTGGTATCGCCGAT | 798 | ||
| GES | F: ATGCGCTTCATTCACGCAC | ||
| R: CTATTTGTCCGTGCTCAGG | 865 | ||
| ClassB | |||
| IMP | F: GGAATAGAGTGGCTTAAYTCTC | ||
| R: GGTTTAAYAAAACAACCACC | 232 | ||
| VIM | F: GCMCTTCTCGCGGAGATTGA | ||
| R: TGCGCAGCACCRGGATAGA | 390 | ||
| NDM | F: GGAATAGAGTGGCTTAAYTCTC | ||
| R: TGCGCAGCACCRGGATAGA | 621 | ||
| ClassD | |||
| OXA-48 | F: GCTTGATCGCCCTCGATT | ||
| R: GATTTGCTCCGTGGCCGAAA | 438 | ||
//bigsdb.pasteur.fr/index.html)查找肺炎克雷伯菌和大肠埃希菌管家基因序列,对21株耐药菌进行PCR。PCR反应条件为95℃ 5 min、95℃ 30 s、退火30 s、72℃ 1 min, 30个循环后72℃ 5 min。将PCR扩增的产物送至北京博迈德生物公司进行测序,测出的序列上网比对后做MLST分析,确定菌株的ST型别。
在耐碳青霉烯阳性菌株筛选出的21株菌中,包括16株肺炎克雷伯菌和5株大肠埃希菌。检出的阳性菌株科室分布分析显示,ICU(42.8%)最多,其次分别为普外科(14.2%)、血液科(9.5%)和全科(9.5%)等。菌株来源显示,尿液标本(28.5%)最多,其次分别为痰液(19.0%)、腹水(14.3%)和胸水(9.5%)等。
21株菌对多数抗生素耐药,所有菌株除了对碳青霉烯类抗生素耐药,对头孢类抗生素和喹诺酮类抗生素均耐药,部分大肠埃希菌对酶抑制剂敏感,药敏结果见表2。

21株耐碳青霉烯肠杆菌科细菌最低抑菌浓度结果(μg/mL)
21株耐碳青霉烯肠杆菌科细菌最低抑菌浓度结果(μg/mL)
| 抗菌药物 | 肺炎克雷伯菌 | 大肠埃希菌 |
|---|---|---|
| 氨苄西林 | ≥32 | ≥32 |
| 阿莫西林/克拉维酸 | ≥32 | ≥32 |
| 哌拉西林/他唑巴坦 | ≥128 | 64~≥128 |
| 头孢唑啉 | ≥64 | ≥64 |
| 头孢西丁 | ≥64 | ≥64 |
| 头孢他啶 | ≥64 | ≥64 |
| 头孢曲松 | ≥64 | ≥64 |
| 头孢吡肟 | ≥64 | ≥64 |
| 氨曲南 | ≥64 | ≥64 |
| 厄他培南 | ≥8 | ≥8 |
| 亚胺培南 | 4~≥16 | ≥16 |
| 美罗培南 | ≥16 | 8~≥16 |
| 阿米卡星 | ≥64 | ≥64 |
| 丁胺卡那霉素 | 16~≥64 | ≤2~≥64 |
| 庆大霉素 | ≤1~≥16 | ≤1~≥16 |
| 妥布霉素 | ≤1~≥16 | ≤1~≥16 |
| 环丙沙星 | ≥4 | ≥4 |
| 左氧氟沙星 | ≥8 | ≥8 |
| 替加环素 | ≤0.5~≥8 | ≤0.5 |
| 呋喃妥因 | ≥512 | ≥512 |
| 复方磺胺甲咪唑 | ≤20~≥320 | 40~≥320 |
21株耐碳青霉烯菌株均进行改良Hodge试验和CIM试验,结果如图1所示。其中15株菌改良Hodge试验和CIM试验结果均为阳性,2株菌均为阴性。另外4株菌改良Hodge试验为阴性但CIM试验阳性。


注:A、C、E是5、6、7、8、19、20号菌株的Hodge试验结果,其中5、7、8、19号菌株为Hodge试验阳性;B、D、F是5、6、7、8、19、20号菌株的CIM试验结果,其中5、7、8、19、20号菌株为CIM试验阳性
21株耐碳青霉烯肠杆菌科细菌进行碳青霉烯酶基因筛查,只检出KPC酶和NDM-1酶,其他碳青霉烯酶未检出。结果显示14株肺炎克雷伯菌产KPC酶,1株肺炎克雷伯菌产NDM-1酶,4株大肠埃希菌产NDM-1酶,另1株肺炎克雷伯菌和1株大肠埃希菌不产碳青霉烯酶。PCR扩增阳性菌株的扩增产物经北京博迈德生物公司进行测序后,序列进行BLAST比对,分析发现14株产KPC酶肺炎克雷伯菌为Kpn SL328 blaKPC-2基因(登录号为KU695994.1,序列符合率为99%);1株产NDM-1酶肺炎克雷伯菌为Kpn AK78 blaNDM-1基因(登录号为KX231917.1,序列符合率为99%);4株产NDM-1酶大肠埃希菌为E.coli Black1 blaNDM-1基因(登录号为KU981021.1,序列符合率为99%) ,结果如图2和图3。


注:M. DNA标准带;"-" . 阴性对照;"+" . 阳性对照

注:M. DNA标准带;"-" . 阴性对照;"+" . 阳性对照
筛选出的21株耐碳青霉烯阳性菌株分别是16株肺炎克雷伯菌和5株大肠埃希菌。用管家基因对19株产碳青霉烯酶的菌株进行PCR并将PCR扩增的产物送至北京博迈德生物公司进行测序,测出的序列在网站(http://bigsdb.pasteur.fr/index.html)比对后做MLST分析。结果为14株产KPC酶的肺炎克雷伯菌均为ST-11型,1株产NDM-1酶的肺炎克雷伯菌为ST-1801型。4株产NDM-1酶大肠埃希菌中有1株是ST-741型,另外3株为ST-39型。
碳青霉烯类抗生素广泛应用于治疗多重耐药革兰氏阴性杆菌引起的严重感染,尤其是产生高水平AmpC酶、头孢菌素酶或ESBLs的菌株[3]。碳青霉烯类抗生素是应对危及生命的感染、重症监护病房和手术移植的关键药物[4]。产生碳青霉烯酶是革兰阴性菌(包括肠杆菌科、铜绿假单胞菌和不动杆菌)对碳青霉烯类抗生素耐药的主要因素。这些碳青霉烯水解酶可以抵抗各种各样的β-内酰胺类抗生素,而且自身接合质粒携带的耐药基因能够在细菌间传播,导致多重耐药性(如对氟喹诺酮类,氨基糖苷类和复方新诺明耐药)传播[5]。临床上常见的碳青霉烯酶包括Ambler-A类、B类及D类:Ambler-A类碳青霉烯酶(KPC、GES),这类酶具有丝氨酸活性位点,可以低水解除头霉素类的β-内酰胺类抗生素;Ambler-B类碳青霉烯酶(NDM、VIM和IMP)是依赖锌离子的金属-β-内酰胺酶,这类酶可以强烈水解除氨曲南以外的β-内酰胺类抗生素;Ambler-D类碳青霉烯类抗生素(OXA)对碳青霉烯类抗生素有弱水解作用,对广谱的头孢菌素和氨曲南没有影响[6,7]。Ambler-C类头孢菌素酶(AmpC cephalosporinases)对碳青霉烯类抗生素有很弱的水解活性[8]。1995年,日本报道了一株质粒携带能够水解碳青霉烯类抗生素blaIMP-1基因的粘质沙雷菌[9]。KPC碳青霉烯酶属于Bush分组的2f组,可以水解碳青霉烯类抗生素、青霉素、头孢菌素和氨曲南,它可被克拉维酸和他唑巴坦抑制[10]。KPC-1在北卡罗莱纳首次从肺炎克雷伯菌株中分离到[11]。随后,KPC-2在肺炎克雷伯菌[12]、沙门氏菌[13]及产酸克雷伯菌分离株[14]中发现。不久,KPC-3在肺炎克雷伯菌[15]和阴沟肠杆菌[16]分离株中发现。KPC-2在中国已有报道,一株在杭州分离的肺炎克雷伯菌中检出了KPC-2[17]。本研究中21株耐碳青霉烯的肠杆菌科细菌中有14株产KPC酶的肺炎克雷伯菌,1株产NDM-1酶的肺炎克雷伯菌,4株产NDM-1酶大肠埃希菌,另外1株肺炎克雷伯菌和1株大肠埃希菌不产碳青霉烯酶。
由于碳青霉烯酶发生率增加,其检测技术的优化是微生物实验室的挑战。为选择适当的治疗方案和实施控制感染的措施,高效及时检测碳青霉烯酶是一个迫切需要解决的问题[18]。一般情况下,产碳青霉烯酶菌株的初步筛选依赖于在药敏试验中对碳青霉烯类药物敏感性降低,还有其他表型检测和生化试验。然而,尽管碳青霉烯酶基因检测在许多实验室不能开展,但分子生物方法仍是检测的金标准[19], 尽管PCR分子检测被认为是检测碳青霉烯酶基因的金标准,但是也有一些局限性,可能会存在假阴性结果(基因突变或未表达)。快速、准确的表型检测方法Carba NP测试,和PCR相比具有很高的敏感性和特异性,而且成本更低。这种方法是CLSI指南推荐的检测方法。然而,最近的研究表明这个方法的灵敏度较低,尤其是对表达较低的碳青霉烯酶(如OXA-48)或产生黏液的菌株[20]。世界卫生组织(WHO)认为抗菌素耐药性是一个亟待解决的问题,特别是产碳青霉烯酶的肠杆菌科细菌已成为全球各国关注的焦点[21],各成员国也正在积极寻求缓解策略。因此,在临床实验室建立高敏感性和特异性的检测方法至关重要。在2015年开发的CIM是一个高敏感性、高特异性且成本低廉的方法[22]。它的检测效果已有报道[23]。另外,2017年CLSI已将CIM列入产碳青霉烯酶的检测方法中[24]。本研究中通过检测21株临床耐碳青霉烯菌株,比较了Hodge试验和CIM试验的性能和特征。其中19株产碳青霉烯酶的菌株(包括KPC和NDM,),经PCR结果和序列分析后,CIM试验检测出了全部的产碳青霉烯酶菌株,而Hodge试验未检测出NDM-1碳青霉烯酶。两株不产碳青霉烯酶的菌株Hodge试验和CIM试验均为阴性。可能存在其他耐药机制如产AmpC和/或ESBL合并渗透性减低。这些结果证明了CIM试验的特异性和阳性预测值为100%。Yamada等[25]研究中,与CIM试验对产碳青霉烯酶菌株的检测相比,Hodge试验检测NDM有假阴性的结果,但其灵敏度(98.8%)和阴性预测值(99%)较高。CIM是一种检测碳青霉烯酶的精确方法,唯一的缺点就是它需要过夜培养才能获得结果。本研究总结得出,CIM有多个优点:(1)操作简单;(2)检测一株菌只需要去离子水和10 μg的美罗培南药敏纸片;(3)一个Mueller-Hinton琼脂板可以检测两株待测菌;(4)结果很容易判读,没有抑菌圈为阳性和有抑菌圈为阴性。总之,CIM有良好的特异性和敏感性,而且低成本(没有专门的试剂、设备或特殊技术),是一种利于在基层医院推广的方法。
利益冲突 无





















